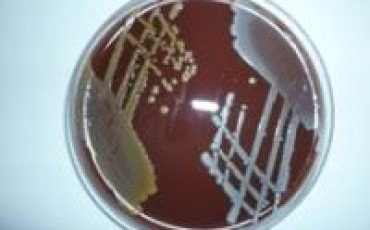

Infectious diseases specialist awarded $75 000 to continue fight against super-bug.
The Ramaciotti Foundations were established in 1970 by Vera Ramaciotti with $6.7 million in funds. Since then, the charitable trusts have donated close to $55 million to biomedical research.
Ramaciotti Establishment Grants of $75 000 are awarded to emerging researchers in universities, public hospitals or institutes undertaking biomedical research. An Establishment Grant is intended to provide enabling research support for a young investigator who is taking, or has recently taken, a substantive research position.
Menzies School of Health Research’s senior clinical research fellow, Dr Josh Davis has received a Ramaciotti Establishment Grant to support his research into infectious diseases.
The $75 000 grant will provide vital seed funding to develop his randomised controlled trials (RCTs) in the areas of Staphylococcus aureus (golden Staph) infections, bone and joint infections and skin infections.
Dr Davis’ project, titled ‘CAMERA2 – Combination Antibiotic Therapy for Methicillin Resistant Staphylococcus Aureus infection. A randomised controlled trial,’ will be conducted at 17 sites in Australia and three in Singapore.
“My priority is to generate high quality scientific evidence to help guide the care of people with severe infections,” Dr Davis commented. “There is actually very little published evidence to guide the way we treat most severe infections.
“Randomised controlled trials, which are less subject to bias, are needed to clarify many key questions in the treatment of severe infections.”
Dr Davis is well aware of the current interest amongst the community in antibiotic-resistant bacteria, due to the increase in prevalence and limited treatment options.
Despite new and expensive antibiotics being trialled for MRSA, none have been found to be better than the standard treatment (Vancomycin). As a result, Dr Davis proposes to combine two cheap and widely available antibiotics to try and improve outcomes from this common and devastating infection.
“The Ramaciotti Establishment Grant will allow me to develop as an Australian leader in the field of clinical trials in severe infections, and will also establish this important RCT.”
For more information about Dr Joshua Davis, visit his researcher profile.